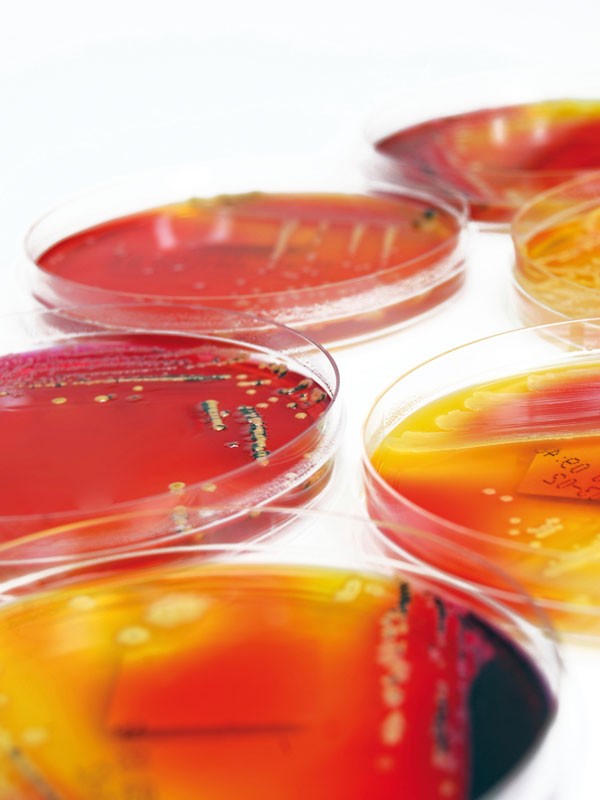

Au niveau hospitalier, la stérilisation est une spécialisation de l’activité visant à la prévention des infections nosocomiales. Cent recommandations pour la surveillance et la prévention des infections nosocomiales ont été édictées par le Ministère de la Santé et nous décrirons ici succinctement les principales d’entre elles. L’organisme chargé du respect des bonnes pratiques de stérilisation s’appelle le CLIN (Comité de Lutte contre les Infections Nosocomiales). Il se réunit périodiquement afin de faire le point sur le respect des règles d’hygiène à travers les signalements qui lui ont été adressés ou par des indicateurs comme, par exemple, la consommation de gel hydro-alcoolique dans chaque service. Le principal paramètre qui différentie l’hôpital du cabinet est le volume d’instruments à traiter. Chaque site possède un service centralisé de stérilisation qui traite les matériels de tous les services. Lorsque le site ne possède pas d’unité de stérilisation, le matériel est prédésinfecté sur place puis expédié dans des containers de grande capacité et sur roulettes vers la stérilisation centrale(fig. 1 et 2).
Un chariot élévateur facilite leur manipulation(fig. 3).
Le responsable de la stérilisation à l’hôpital est le pharmacien. Il est secondé par le personnel de la pharmacie et par des agents de stérilisation dont la mission principale est de nettoyer, conditionner et stériliser les équipements et les matériels médicaux afin d’éradiquer les agents infectieux susceptibles de propager des infections. Leur fiche métier précise « qu’ils doivent faire preuve de rigueur et de méthode. Ce sont des personnes organisées, qui maîtrisent les protocoles et les règles d’hygiène et de sécurité du matériel. Autonomes, ils planifient leur temps en…